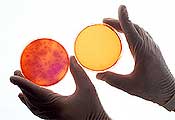

vampiros energeticos

Sanación
y Salud
Sanación y Salud: reiki para sanar y sentirse bien
Inicio > Documentación > Estudios realizados Maestro de Reiki: John Curtin
Sanación a Distancia - Estudios realizados
Los investigadores se fijan en el poder de la oración
Hilary E. MacGregor. Los Angeles Times
Jun. 1, 2005 03:11 PM
SAN FRANCISCO - Sobre una mesa de operaciones en un centro médico en San Francisco, una paciente de cáncer de mama se somete a una cirugía reconstructiva después de una mastectomía. Pero ésta no será una cirugía ordinaria. Un sanador chamánico a tres mil millas de distancia ha recibido el nombre de la mujer, una foto y detalles acerca de la operación.
En cada uno de los siguientes ocho días, el sanador rezará durante 20 minutos por la recuperación de la paciente con cáncer, sin que ésta lo sepa. Un cirujano ha insertado dos pequeños tubos de fábrica dentro de la ingle de la mujer para permitir a los investigadores saber lo rápido que sana.
 La mujer es una paciente en un estudio extraordinario llevado a cabo por el gobierno que quiere determinar si la oración tiene el poder de sanar pacientes desde lejos - un campo conocido como "sanación a distancia". Mientras que este término no le sea probablemente familiar a la mayoría de los americanos, la idea de rezar en sus casas, hospitales y lugares de culto no lo es. En los años recientes, la medicina ha mostrado un
interés creciente en investigar los efectos de la oración y la espiritualidad sobre la salud. Una encuesta sobre 31.000 adultos efectuada el año pasado por el Centro para el Control y la Prevención de la Enfermedad encontró que el 43 por
ciento de los adultos de los E.E.U.U. rezaban por su propia salud, mientras que el 24 por ciento tenían a otros rezando por
su salud.
La mujer es una paciente en un estudio extraordinario llevado a cabo por el gobierno que quiere determinar si la oración tiene el poder de sanar pacientes desde lejos - un campo conocido como "sanación a distancia". Mientras que este término no le sea probablemente familiar a la mayoría de los americanos, la idea de rezar en sus casas, hospitales y lugares de culto no lo es. En los años recientes, la medicina ha mostrado un
interés creciente en investigar los efectos de la oración y la espiritualidad sobre la salud. Una encuesta sobre 31.000 adultos efectuada el año pasado por el Centro para el Control y la Prevención de la Enfermedad encontró que el 43 por
ciento de los adultos de los E.E.U.U. rezaban por su propia salud, mientras que el 24 por ciento tenían a otros rezando por
su salud.
Algunos investigadores dicen que esta razón es suficiente para estudiar el poder de la oración.
"Casi cada comunidad en el mundo tiene una oración para la enfermedad, que practican cuando un miembro de su comunidad está enfermo," dijo Dr. Mitchell Krucoff, un cardiólogo de la Universidad Duke e investigador en el campo de la oración y la sanación a distancia. "Es una practica cultural ubicua, hasta donde podemos contar… Las prácticas culturales en el cuidado de la salud frecuentemente tienen una razón. Pero entender esta razón, aprender el mejor modo de usarla, requiere ciencia clínica básica".
 La ciencia sólo ha comenzado a explorar el poder de la sanación a distancia, y los primeros resultados de esta investigación no han llegado a una conclusión. En un artículo publicado en los Anales de Medicina Interna en 2000, investigadores reportaron 23 estudios acerca de técnicas de sanación a distancia, que incluían sanación religiosa, energética y espiritual. Trece de los 23 estudios indicaron que existen efectos
positivos en la sanación a distancia, nueve estudios no encontraron efectos beneficiosos y uno mostraba un modesto efecto negativo en el uso de sanación a distancia.
La ciencia sólo ha comenzado a explorar el poder de la sanación a distancia, y los primeros resultados de esta investigación no han llegado a una conclusión. En un artículo publicado en los Anales de Medicina Interna en 2000, investigadores reportaron 23 estudios acerca de técnicas de sanación a distancia, que incluían sanación religiosa, energética y espiritual. Trece de los 23 estudios indicaron que existen efectos
positivos en la sanación a distancia, nueve estudios no encontraron efectos beneficiosos y uno mostraba un modesto efecto negativo en el uso de sanación a distancia.
El estudio de la sanación a distancia fue una vez el campo de excéntricos científicos, pero investigadores de instituciones tan prominentes como el Instituto Médico
 Mente/Cuerpo en Chestnut Hill, Massachuset, el Centro Médico de la Universidad Duke en Carolina del Norte y el Centro Médico California Pacific en San Francisco se han introducido en este asunto. Y los Institutos Nacionales del Centro de Salud Nacional para la Medicina Complementaria y Alternativa han gastado 2,2 millones de dólares en estudios sobre la sanación a distancia
y la oración de intercesión desde 2000 - una pequeña fracción del presupuesto anual de la agencia, que sumó un total de 117 millones de dólares en 2004.
Mente/Cuerpo en Chestnut Hill, Massachuset, el Centro Médico de la Universidad Duke en Carolina del Norte y el Centro Médico California Pacific en San Francisco se han introducido en este asunto. Y los Institutos Nacionales del Centro de Salud Nacional para la Medicina Complementaria y Alternativa han gastado 2,2 millones de dólares en estudios sobre la sanación a distancia
y la oración de intercesión desde 2000 - una pequeña fracción del presupuesto anual de la agencia, que sumó un total de 117 millones de dólares en 2004.
Algunas personas piensan que esta relativamente pequeña suma de dinero no está bien empleada.
"No puedes usar la ciencia para probar a Dios," dijo John T. Chibnall, un profesor asociado de psiquiatría en la Escuela de Medicina de la Universidad de St. Louis en Missouri, quien co-escribió una mordaz refutación de los estudios acerca de la sanación a distancia publicados en los Archivos de Medicina Interna en 2001. "No deberíamos malgastar el dinero del gobierno mostrando que Jesús es 'el hombre'," dijo Chibnall en una entrevista. "La fé es la fé. La ciencia es la ciencia. No useis la ciencia para aumentar o disminuir la creencia en Dios."
 Mientras algunos científicos se oponen a estos estudios sobre materias religiosas o científicas, otros se preguntan si es posible trazar un método científico válido para medir algo tan nebuloso como el poder de la oración.
Mientras algunos científicos se oponen a estos estudios sobre materias religiosas o científicas, otros se preguntan si es posible trazar un método científico válido para medir algo tan nebuloso como el poder de la oración.
¿Qué constituye una "dosis" de oración?
¿Cómo define uno la oración? ¿Es canalizar
la intención budista o la energía Reiki lo mismo que
rezar al Dios judeocristiano? ¿Y cómo determinas si
fue la oración lo que hizo que el paciente se pusiera mejor,
u otra cosa, como el efecto placebo?
"Hay enormes problemas metodológicos y conceptuales con los estudios sobre la sanación a distancia," dijo el Doctor Richard Sloan, un profesor de medicina del comportamiento en la Universidad de Columbia en Nueva York. "Nada en nuestra comprensión del universo o de nosotros mismos sugiere cómo los pensamientos de un grupo de gente podrían influir la fisiología de personas a 3.000 millas de distancia."
El cardiólogo Randolph Byrd hizo el primer estudio clínico sobre sanación a distancia en el Hospital General de San Francisco en 1988. Dividió a 393 pacientes cardiacos en dos grupos.
El cardiólogo Randolph Byrd hizo el primer estudio clínico sobre sanación a distancia en el Hospital General de San Francisco en 1988. Dividió a 393 pacientes cardiacos en dos grupos.
Un grupo recibió oraciones de cristianos fuera del hospital; el otro, no. Su estudio, publicado en el Southern Medical Journal, encontró que los pacientes por los que no se rezó necesitaron más medicación y fueron más propensos
a sufrir complicaciones. Aunque tenía fallos, el estudio generó una considerable atención.
Desde entonces, los investigadores han continuado observando los posibles efectos de la oración remota y otras técnicas de sanación a distancia similares en el tratamiento de afecciones del corazón, SIDA y otras enfermedades así como en la infertilidad. Numerosos experimentos que incluían oración y sanación a distancia han sido también hechos sobre animales y plantas. Uno de dichos estudios encontró que los sanadores podían incrementar la tasa de sanación de heridas en ratones.
 "Los críticos normalmente se quejan si ves resultados positivos en humanos porque lo achacan al pensamiento positivo, o al efecto placebo," dijo el Doctor Larry Dossey, un interno retirado en Santa Fe, y autor de numerosos libros sobre espiritualidad
y sanación. "Los microbios no piensan positivamente, y no están sujetos a la respuesta placebo."
"Los críticos normalmente se quejan si ves resultados positivos en humanos porque lo achacan al pensamiento positivo, o al efecto placebo," dijo el Doctor Larry Dossey, un interno retirado en Santa Fe, y autor de numerosos libros sobre espiritualidad
y sanación. "Los microbios no piensan positivamente, y no están sujetos a la respuesta placebo."
En los primeros noventa, Elisabeth Targ y unos colegas en el Centro Médico California Pacific estudiaron los efectos de la sanación a distancia sobre 20 pacientes de SIDA. Schlitz, que trabajó con Targ (que murió de un tumor cerebral en 2002), dijo que el estudio encontró que aquellos que recibieron oraciones sobrevivieron en mayor número, se enfermaron menos frecuentemente
y se recuperaron más deprisa que los otros. Un posterior estudio que siguió a 40 pacientes encontró resultados
similares.
Aproximadamente al mismo tiempo, Krucoff de la Universidad Duke estaba liderando un pequeño pero inusual experimento para determinar si pacientes cardiacos se recuperarían más rápido tras la cirugía angioplástica si recibían cualquiera de varios tratamientos intangibles. Su estudio comparó los resultados de Healing Touch, relajación del estrés, y sanación a distancia con los cuidados normales.
 Sanadores espirituales de todo el mundo-incluyendo judíos elevando plegarias en el Muro de las Lamentaciones en Jerusalén, budistas rezando en monasterios en Nepal y Francia, monjas carmelitas en Baltimore ofreciendo oraciones durante las vísperas, y moravianos, baptistas y cristianos fundamentalistas rezando en la iglesia - rezaban simultáneamente por uno de los distintos grupos designados en el estudio.
Sanadores espirituales de todo el mundo-incluyendo judíos elevando plegarias en el Muro de las Lamentaciones en Jerusalén, budistas rezando en monasterios en Nepal y Francia, monjas carmelitas en Baltimore ofreciendo oraciones durante las vísperas, y moravianos, baptistas y cristianos fundamentalistas rezando en la iglesia - rezaban simultáneamente por uno de los distintos grupos designados en el estudio.
Todos los grupos fueron mejor que el grupo que sólo recibió los cuidados habituales, pero aquellos que recibían oraciones a distancia fueron los mejores. Desde entonces, ha completado un estudio mayor y desde múltiples sitios. Ese estudio - el más completo hasta la fecha - se encuentra en estos momentos en revisión para su publicación en una revista médica.
Volver a Documentación
Páginas relacionadas:
- Qué es Reiki
- Qué se siente durante un tratamiento.
- Qué puede hacer Reiki por mi
Inicio | Qué es Reiki | Tratamientos | Cursos | Documentación | Meditaciones | Foro | English Version
Derechos de autor:
Todos los gráficos, contenidos y estilos de diseño en esta web son propiedad
intelectual de la Fundación Sauce, excepto cuando se especifica lo contrario.
©
Fundación Sauce, 2006
Fundación Sauce, C/ Sandoval 8, 28010 Madrid, España, Tel. 91 591 99 95 CIF G84458934


 Charla informativa sobre Reiki
Charla informativa sobre Reiki





